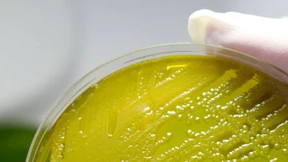
Der verflüchtigte Erreger

Krebs gewinnt Landratswahl
Ulrich Krebs (CDU) hat Norman Dießner hinter sich gelassen und bleibt Landrat des Hochtaunuskreises. Er ist mit 63,3 Prozent der Stimmen für weitere sechs Jahre wiedergewählt worden.

Ulrich Krebs (CDU) hat Norman Dießner hinter sich gelassen und bleibt Landrat des Hochtaunuskreises. Er ist mit 63,3 Prozent der Stimmen für weitere sechs Jahre wiedergewählt worden.
Sechs Monate nach dem Ende der Ehec-Epidemie ist auch die Welt um den Erlenbach in Frankfurt wieder in Ordnung.

Der junge Mann im dunklen Anzug und mit gestreifter Krawatte, der dynamisch auf den Betrachter zuläuft, ist der Kandidat der Grünen. Das ist in einer Zeit, in der viele Ortsverbände der Partei den 30.Gründungstag gefeiert haben, kaum weiter bemerkenswert.

Viel in einen Landratswahlkampf zu investieren, hätte früher im Taunus kaum für die Grünen die Mühe gelohnt. Doch seitdem sie auch Oberbürgermeister stellt, gibt sich die Partei zuversichtlich.

Königstein und Kronberg schließen sich mit Glashütten und Steinbach zu einem Standesamtsbezirk zusammen und bieten mehr Auswahl für das passende Hochzeitsambiente.

Am Frankfurter Flughafen hat Deutschlands einzige Flughafen-Spielbank neu eröffnet. Die Brandschutz-Ertüchtigung hatte für fast vier Jahre ein Provisorium erzwungen.

Islamische Interessengruppen wollen auf den Malediven Wellness verbieten. Sie vermuten „versteckte Bordelle“ in den Spas und Massagesalons und kritisieren das Servieren von Alkohol und Schweinefleisch.

Orkan über Hessen: „Andrea“ knickte Bäume um, warf einen Container von einem Schiff und kippte einen Lastwagen um. Aber es ging glimpflich ab.

Die geplanten Kampagnen der bekannten Bewerber für die Oberbürgermeisterwahl unterscheiden sich deutlich. Ginge es nur nach dem Budget, stünden die Stichwahl-Kandidaten schon fest.

2011 geht als schwaches Aktienjahr in die Börsengeschichte ein. Dennoch ließ sich mit Aktien gutes Geld verdienen. Die besten Titel im Dax kommen aus Rhein-Main - dort sitzt auch der Gesamtsieger.

Nur bei 18 Aktien der 100 Werte des F.A.Z.-Index sind die Kurse gestiegen. Genauso viele verbuchten dagegen Verluste von mehr als 40 Prozent.

Fresenius erhöht die Gewinnerwartungen, AT&T gibt die Übernahme von T-Mobile USA auf. Der Auftragseingang von Süss Microtec liegt unter den Erwartungen, Nordex hofft auf schwarze Zahlen im kommenden Jahr. Die europäischen Länder stocken die IWF-Mittel zur Bekämpfung der Schuldenkrise auf und der private Verbrauch wird in Deutschland 2012 wohl leicht zulegen.

Der Hut gehörte über viele Jahrhunderte hinweg zum Mann wie seine Männlichkeit und vor kurzem noch zum Bürger wie seine Bürgerlichkeit. Wo ist er geblieben?

Das Immobiliengeschäft ist eingebrochen, von der Energiewende profitiert die Leasinggesellschaft der Sparkassen.

Der österreichische Kabarettist Georg Kreisler ist tot. Der Neunundachtzigjährige starb am Dienstagmorgen nach einer schweren Infektion in einem Salzburger Krankenhaus.

Gelebte Entschleunigung auf der Autobahn 5 nach einem Lastwagenbrand.

Fast sechs Millionen Euro aus Auflagen und Bußgeldern haben hessische Staatsanwälte und Richter im vergangenen Jahr an gemeinnützige Vereine im Land überweisen lassen.
Es spricht viel dafür, dass die 75 Millionen Euro, die die Erweiterung des Main-Taunus-Zentrums gekostet hat, gut angelegtes Geld sind. Weit abgeschlagen sind dagegen einige Konkurrenten aus der Region.

Dell gibt sich vorsichtig, Baloise warnt vor einem Gewinneinbruch. Bouygues erhöht die Umsatzprognose, Vivendi verzeichnet ein zweistelliges Gewinnplus. Bayer setzt auf die Expansion in Asien, Vodafone will angeblich das KPN-Geschäft in Spanien kaufen, Fresenius für 180 Millionen Euro FMC-Aktien. Die japanische Notenbank hält an ihrer Nullzinspolitik fest, Brüssel rudert bei der Regulierung der Ratingagenturen zurück und die Bundesbank spricht sich gegen eine Aufspaltung von Banken aus.

Die Stadt Bad Homburg testet einen Hybridbus, der den Dieselverbrauch deutlich senken soll. Anlass ist die hohe Feinstaubbelastung im Kurbezirk.
Nach einem schweren Unfall auf der A5 bei Bad Homburg sucht die Polizei nach dem Fahrer der Unglückswagens. Der Mann war von Lasterfahrern gerettet worden und anschließend geflüchtet.

Parktickets, die Müllabfuhr, der Eintritt in städtische Bäder und anderes sollen von Januar an in Wiesbaden teurer werden. Die Zustimmung der Stadtverordneten gilt als sicher.

Der Hessische Städte- und Gemeindebund hat sich dafür ausgesprochen, den Rechtsanspruch von Eltern auf die Betreuung von Kleinkindern nicht schon 2013 gelten zu lassen.

Caterer wollen sich Anteile an dem Zukunftsmarkt sichern. Die Schulträger sind bei der Vergabe an Kriterien gebunden.

Das English Theatre Frankfurt produziert den Musical-Klassiker „Tommy“. Mit den Profis proben in London zwei hessische Kinder.

Der Bad Homburger Etatentwurf für 2012/13 ist ausgeglichen. Dafür müssen Bürger und Unternehmen mit höheren Abgaben rechnen.

Auch Fresenius zeigt ein starkes Quartal, Gea überrascht mit einem hohen Gewinnsprung und Hugo Boss bekräftigt die Prognose. Auch Hertz und Standard Chartered steigern den Gewinn, aber Sony rechnet mit hohen Verlusten. Ein griechischer Investor will Kaufhof übernehmen und die Autoverkäufe in Amerika sind im Oktober gestiegen.

Man muss kein Grüner sein, um den Abschied Manuela Rottmanns aus der Frankfurter Stadtpolitik zu bedauern.

Eine überparteiliche Mediatorengruppe hat Vorschläge zur Reform des kommunalen Finanzausgleichs präsentiert. Ärmere Städte sollen künftig weniger Geld abgeben.

Von wegen Alterssitz: Der einst in der Rolle des Jungmillionärs Percy Stuart bekannt gewordene Schauspieler Claus Wilcke ist als Neu-Bad-Homburger viel unterwegs.

Bad Homburg will als Kurstadt und Modebad des 19.Jahrhunderts auf die Welterbe-Liste der Unesco gesetzt werden.
olko. IDSTEIN. "Erleben! Erfahren! Erlernen!" Geht es nach den Studenten der Bad Homburger Accadis-Hochschule, bilden die drei Schlagworte in Zukunft den Idsteiner Tourismus-Slogan. Das Motto ist Bestandteil eines umfangreichen Fremdenverkehrskonzeptes, ...
rsch./bie. Rhein-Main. Wie schon im vergangenen Jahr präsentiert sich die Metropolregion Frankfurt/Rhein-Main auch bei der diesjährigen Immobilienmesse Expo Real vom 4. bis 6. Oktober in München wieder an einem Gemeinschaftsstand.
bie. BAD HOMBURG. An der Kalbacher Straße im Stadtteil Ober-Eschbach soll die Stadt ein Bebauungskonzept für preiswerte seniorengerechte Mietwohnungen mit integrierten Betreuungs- und Serviceangeboten entwickeln.
bie. BAD HOMBURG. Im nächsten Frühjahr sollen die Bad Homburger wieder durch den Gustavsgarten wandeln können. Die Stadtverordneten haben am Donnerstagabend einstimmig beschlossen, das historische Parkgelände zwischen Tannenwaldallee und Mariannenweg mit einem Bebauungsplan zu sichern.
bie. BAD HOMBURG. Die Stadt ist am Kauf von Anteilen am regionalen Energieversorger Süwag AG interessiert. Bei Enthaltung von Wolfgang Hof (FDP) haben die Stadtverordneten auf Antrag der CDU den Magistrat einstimmig mit der wirtschaftlichen Prüfung beauftragt.